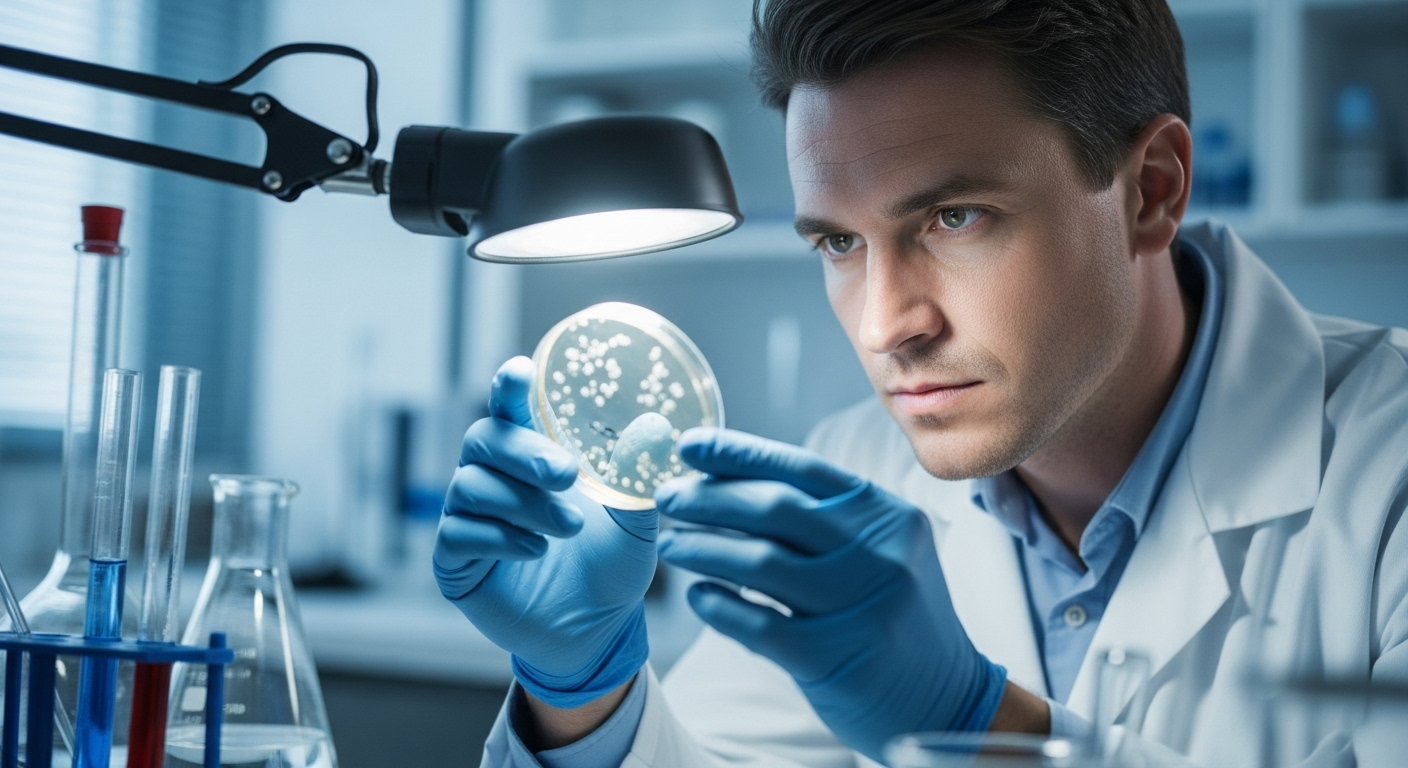
Comment les chercheurs ont-ils prouvé son efficacité ?

Un nouvel espoir contre le paludisme : un traitement prometteur testé avec succès
Auteur: Mathieu Gagnon
Le paludisme, vous en avez sûrement déjà entendu parler. C’est une maladie terrible qui, malheureusement, continue de faire des ravages, surtout chez les plus jeunes en Afrique. Imaginez, chaque année, elle emporte plus de 600 000 personnes dans le monde, principalement des enfants. Les traitements et vaccins actuels aident, bien sûr, mais leur efficacité n’est pas toujours au rendez-vous.
Mais aujourd’hui, une nouvelle vraiment encourageante nous vient des scientifiques. Une étude récente a montré qu’un tout nouveau traitement pourrait changer la donne et protéger efficacement contre cette maladie. C’est une vraie lueur d’espoir pour des millions de familles.
Qu'est-ce que ce nouveau traitement exactement ?

Alors, de quoi s’agit-il ? Ce n’est pas un vaccin comme les autres. On l’appelle un « anticorps monoclonal ». C’est un mot un peu compliqué, mais l’idée est assez simple. Ce sont des protéines, fabriquées en laboratoire, qui sont conçues pour imiter les défenses naturelles de notre corps.
Ce nouvel anticorps, baptisé MAM01, est un véritable garde du corps. Il cible directement le parasite responsable du paludisme, le Plasmodium falciparum, juste au moment où il essaie d’infecter notre organisme. En gros, il l’arrête net avant même que l’infection n’ait le temps de commencer. C’est une approche vraiment différente et très intelligente.
Comment les chercheurs ont-ils prouvé son efficacité ?
Pour être sûrs que ça marche, les chercheurs de l’École de Médecine de l’Université du Maryland ont mené un essai très sérieux. Ils ont réuni un groupe de 38 adultes en bonne santé, qui n’avaient jamais eu le paludisme.
Certains ont reçu une dose du nouveau traitement, et les autres, un placebo (un produit sans effet, juste pour comparer). Plusieurs mois après, tous les volontaires ont été exposés, de manière très contrôlée et sécurisée, à des piqûres de moustiques porteurs du parasite. C’est ce qu’on appelle une étude de provocation, et c’est ce qui permet de voir si la protection est réelle.
Des résultats spectaculaires et sans danger

Et les résultats sont allés bien au-delà des espérances. C’est simple : aucune des personnes qui ont reçu la plus forte dose de l’anticorps n’a développé le paludisme. Zéro infection ! En comparaison, toutes les personnes qui avaient reçu le placebo sont tombées malades. La protection a été totale.
Et ce qui est tout aussi important, c’est qu’il n’y a eu aucun effet secondaire grave lié au traitement. C’est donc non seulement efficace, mais aussi très bien toléré par l’organisme.
En quoi est-ce mieux qu'un vaccin classique ?

La grande force de ce traitement, c’est sa simplicité et sa rapidité d’action. Comme l’explique la professeure Kirsten E. Lyke, qui a dirigé l’étude, « contrairement aux vaccins qui peuvent nécessiter plusieurs doses ou rappels, une seule injection d’un anticorps à longue durée d’action pourrait offrir une protection immédiate de plusieurs mois« .
C’est une révolution, surtout pour les populations les plus fragiles comme les très jeunes enfants ou les femmes enceintes. Plus besoin d’un calendrier de vaccination complexe, une seule piqûre suffirait pour être protégé durablement. C’est une façon de « stopper l’infection avant qu’elle ne commence », comme le dit si bien la chercheuse.
Quelles sont les prochaines étapes ?

Cette réussite est une étape majeure, mais le travail n’est pas fini. L’équipe de recherche travaille déjà à optimiser les doses pour que le traitement soit le plus efficace et le moins cher possible. L’objectif est de rendre cette protection accessible à tous dans les régions où le paludisme fait le plus de dégâts.
D’ailleurs, les choses avancent vite : des tests ont déjà commencé sur de jeunes enfants en Ouganda, forts des résultats très prometteurs de cette première étude. C’est la preuve que cet espoir est en train de devenir une réalité concrète sur le terrain.
Conclusion : Vers un avenir sans paludisme ?

En résumé, cette découverte est bien plus qu’une simple avancée scientifique. C’est une promesse immense pour des millions de personnes. Un traitement simple, sous forme d’une seule injection, capable de protéger du paludisme pendant des mois et sans danger, pourrait véritablement changer le cours de l’histoire de cette maladie.
Bien sûr, il reste du chemin à parcourir, mais l’espoir est immense. Grâce à des recherches comme celle-ci, l’idée d’un monde où les enfants n’auraient plus à craindre le paludisme semble, pour la première fois, un peu plus à notre portée.
Selon la source : medicalxpress.com










